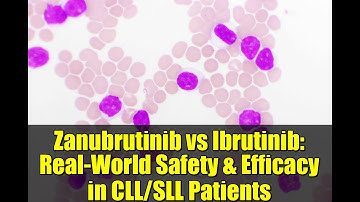
Zanubrutinib vs Ibrutinib: Real-World Safety & Efficacy in CLL/SLL Patients

⬇ DOWNLOAD NOW
Kalau muncul iklan pop-up, tutup lalu klik tombol kembali
Download lagu A real-world analysis of CNS involvement in CLL secara gratis hanya untuk keperluan promosi. Dukung artis favorit kamu dengan membeli musik original di iTunes atau platform resmi lainnya.
 Real-world safety and efficacy of first- and second-generation BTK inhibitors in CLL
Real-world safety and efficacy of first- and second-generation BTK inhibitors in CLL
 Overall survival associated with real-world treatment sequences in patients with CLL/SLL in the US
Overall survival associated with real-world treatment sequences in patients with CLL/SLL in the US
 Getting involved in real-world studies for CLL through ERIC
Getting involved in real-world studies for CLL through ERIC
Zanubrutinib vs Ibrutinib: Real-World Safety & Efficacy in CLL/SLL Patients
Zanubrutinib vs Ibrutinib: Real-World Safety & Efficacy in CLL/SLL Patients
 Zanubrutinib vs Ibrutinib: Real-World Safety & Efficacy in CLL/SLL Patients
Zanubrutinib vs Ibrutinib: Real-World Safety & Efficacy in CLL/SLL Patients
 Real-world comparison of TTNT with ibrutinib or acalabrutinib in CLL
Real-world comparison of TTNT with ibrutinib or acalabrutinib in CLL
 Projections from real world evidence of CLL management
Projections from real world evidence of CLL management
 Adam Kittai, MD, Discusses Racial Disparities in CLL Survival Outcomes
Adam Kittai, MD, Discusses Racial Disparities in CLL Survival Outcomes